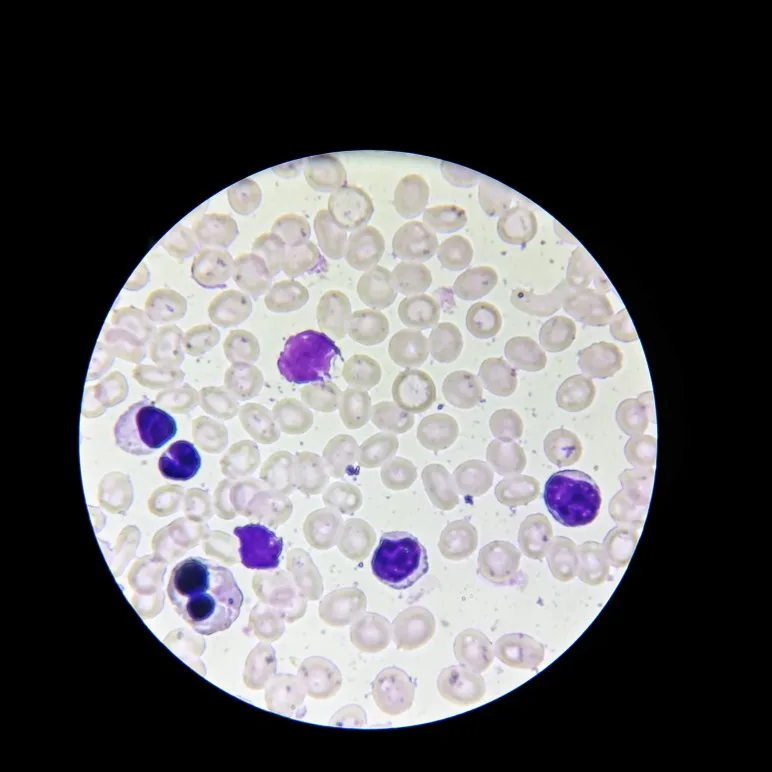

Биологический микроскоп план объектив 4X 10X 20X 40X 60X 100X резьба RMS 160/0.17
15.92
–
81.82
$
78
заказов
/
15
отзывов
История цены
- за 3 месяца
- за полгода
- требуется расширение Alitools
Чтобы следить за товаром и получать уведомления о падении цены, требуется расширение Alitools.
Уведомление о падении цены
15.12 $ (-5%)
15.12 $ (-5%)
14.33 $ (-10%)
13.53 $ (-15%)
12.74 $ (-20%)
Наш Telegram bot уведомит вас как только цена упадет до желаемой
Этот товар у других продавцов
Похожие товары
Отзывы покупателей
v***a
12 января 2021
Оригинальный аналогичный объектив олиипус - 45000. Пока не заметил недостатков, обусловливающих разницу в цене. И вообще не заметил
K***n
4 января 2021
Упаковано хорошо. Пришло быстро.
Аноним